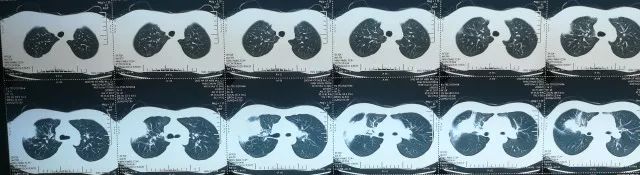
如何在CAP初始治疗后72h内进行病情评价?其成功关键有哪些?

推荐语
15岁男孩持续性发热伴咳嗽一月有余,体温最高39.0℃,经当地医院诊断为肺炎,治疗好转后出院,但患者很快再次出现发热,遂入住河北医科大学第二医院……
其入院CT报告结果如何?为何这位患者抗生素初始治疗失败了?是因其他特殊病原体感染吗?拟调整抗感染方案后,患者的体温、血常规等辅助检查、胸部CT报告结果如何?
社区获得性肺炎的临床诊断标准有哪些?初始经验性抗感染药物如何选择?初始治疗后72h内如何进行病情评价?初始经验治疗成功的关键又有哪些?河北医科大学第二医院孟爱宏、周广伟医生带来这份经典病例并对此做了解答。
韩XX,男性,15岁,汉族,学生,河北省邢台市。
主诉:发热伴咳嗽1月余,加重3天。
现病史:患者于1月前冲凉后出现发热,体温最高39.0℃,为持续性发热,伴发冷寒颤,伴咳嗽咳痰,咳黄色脓痰,伴鼻塞流涕,伴四肢肌肉酸软乏力,无头晕、头痛,无腹痛、腹泻,无尿频、尿急、尿痛,就诊于当地医院,诊断为「肺炎」,给予其「头孢呋辛钠、阿奇霉素、盐酸溴己新」等药物治疗后,症状较前好转,体温降至正常后出院。患者于3天前再次出现发热,体温最高37.5℃,现为求进一步诊治收入我科。
患者自发病以来,精神、饮食、睡眠可,二便正常,体重较前无明显变化。
既往史:既往体健;否认高血压、冠心病、糖尿病病史;否认肝炎、结核传染病病史;否认外伤及输血史;否认近日呛咳、误吸史;否认近日皮肤感染、外伤史;否认药物及食物过敏史;预防接种史不详,系统回顾无特殊。
个人史:生于原籍,久居当地,未到过疫区及牧区,有间断吸烟饮酒史,具体量不详。否认性病及冶游史。
婚育史:未婚。
家族史:父母健在,家族中无糖尿病、冠心病等相关性疾病病史,无结核、肝炎等传染性疾病及类似疾病可记述。
体格检查:T 37.2℃,P 79次/分,R 18次/分,BP 103/66 mmHg。
发育正常,营养中等,自主体位,查体合作。全身皮肤、粘膜无黄染,未见出血点、瘀点、瘀斑,未见肝掌及蜘蛛痣。周身浅表淋巴结未触及肿大。头颅无畸形,眼睑无水肿,结膜无苍白,巩膜无黄染。两侧瞳孔等大正圆,对光反射灵敏。咽部无充血,扁桃体无肿大。双肺呼吸音粗,右肺可闻及湿性啰音。心率79次/分,律齐,各瓣膜听诊区未闻及杂音。腹部平坦,未见腹壁静脉曲张,腹软,无反跳痛及肌紧张,肝脾肋下未触及,Murphy征阴性,叩鼓音,移动性浊音阴性,肠鸣音正常存在,肝区、双肾区无叩击痛。双下肢无水肿。
辅助检查:
血常规:

生化:

电解质、肾功能未见异常

尿沉渣潜血: ++
肾及肾静脉彩超示:
1、双肾实质部回声稍强;
2、双肾静脉血流未见异常
PS:胡桃夹现象:左肾静脉受压,是指左肾静脉回流入下腔静脉过程中在穿经由腹主动脉和肠系膜上动脉形成夹角,或腹主动脉与脊柱之间间隙内受到挤压,常伴有左肾静脉血流速度的下降、受压远端静脉的扩张。
呼吸道病原体:支原体抗体IgM 阳性,滴度:1:1280(06-13) 1:640 (06-15)
入院时炎性指标:
CRP 103.7mg/L、PCT、D- Dimer、pro-BNP未见异常
ESR:31mm/h

心电图:正常心电图
入院CT报告(2017-06-11):
1、右肺上叶-中叶见团块状软组织密度影,周边可见磨玻璃密度影,病变大小约5.08*3.38cm,CT值约25HU,其内密度不均,中心可见低密度影,CT值约5HU,病变与胸膜宽基底相连,与右侧横膈胸膜分界不清,建议增强进一步检查。
2、右肺上叶前段支气管欠通畅,建议复查。
3、右肺上叶、中叶、下叶内基底段条索
4、右侧胸膜增厚,右侧少许胸腔积液
5、纵隔内、两侧腋窝下小淋巴结,前纵隔软组织密度影,考虑未退化完全胸腺组织。
CAP的临床诊断标准
1、社区发病:强调社区发病
2、肺炎相关临床表现
● 新近出现的咳嗽、咳痰或原有呼吸道疾病症状加重,伴或不伴脓痰/胸痛/呼吸困难/咯血
● 发热
● 肺实变体征和(或)闻及湿啰音
●外周血白细胞(WBC)>10×10^9/L或<4×10^9/L,伴或不伴细胞核左移
3、胸部影像学检查
胸部影像学检查显示新出现的斑片状浸润影、叶/段实变影、磨玻璃影或间质性改变,伴或不伴胸腔积液。
符合1、3及2中任何1项,并除外肺结核、肺部肿瘤、非感染性肺间质性疾病、肺水肿、肺不张、肺栓塞、肺嗜酸性粒细胞浸润症及肺血管炎等后,可建立临床诊断。
初步诊断:
1、社区获得性肺炎(细菌+支原体)
2、肝功能损伤
CAP初始经验性抗感染药物选择:


治疗方案
1、注射用头孢孟多酯钠 2.0g Tid
注射用阿奇霉素 500mg Qd
2、同时给予化痰、保肝、调节免疫力等辅助治疗
治疗效果评价:
● 患者仍间断有发热,每日最高体温最高仍可接近38℃。
● 抗生素应用72小时后体温无明显下降趋势,考虑抗生素初始治疗失败。
● 失败原因:特殊病原体感染?(TB?、MDR菌?真菌?其它特殊病原体?)
拟调整抗感染方案
拟经验性升级抗生素至比阿培南,继续应用阿奇霉素抗支原体。
同时积极完善病原学检查。
支气管镜:

灌洗液培养示:耐甲氧西林金黄色葡萄球菌(MRSA)
病理涂片示:(支气管灌洗液)涂片可见多量中性粒细胞及少量吞噬细胞。
修正诊断:
1、社区获得性肺炎(耐甲氧西林金黄色葡萄球菌+支原体)
2、肝功能损伤
调整治疗方案
1、注射用阿奇霉素 0.5g Qd
注射用盐酸去甲万古霉素 0.8 Bid
停用头孢孟多酯钠
2、同时给予化痰、保肝、调节免疫力等辅助治疗
用药后体温:

辅助检查:
血常规:

生化:

电解质、肾功能未见异常
复查胸部CT报告:
1、右肺病变较前略有变化,部分减轻,尖段病变增多,请结合病原学检查;
2、右侧少许胸腔积液基本吸收;
3、纵隔及两侧腋窝多发淋巴结部分稍增大,较前未见明显变化。
余大致同前。

(2017年6月11日)

(2017年6月22日)
出院前一天,患者CT片结果如下:(2017年6月30日):

出院之后,家属不放心,又在门诊陆续复查了几次,且看患者恢复情况:

(2017年7月27日)

(2017年12月28日)
病例特点
15岁男性,急性起病。症状以持续发热伴咳嗽咳痰为主要表现;查体双肺呼吸音粗,右肺湿啰音;应用头孢孟多后仍有发热,病情反复,使用去甲万古霉素后体温下降,各项炎性指标下降,病情趋于稳定。
● 肺炎支原体和肺炎链球菌是我国成人CAP主要病原体
● 其他常见病原体包括流感嗜血杆菌、肺炎衣原体、肺炎克雷伯菌及金黄色葡萄球菌
● 铜绿假单胞菌、鲍曼不动杆菌少见

纳入2003年12月至2004年11月中国7个城市12个中心的665例CAP患者,进行病原体检测 [1]

纳入首都医科大学北京世纪坛医院6539例发热门诊患者,其中确诊为CAP患者402例 [2]

1、多项研究显示:革兰氏阴性菌(大肠埃希菌与肺炎克雷伯菌)检出率较低 [1] [2] ,且多见于特殊人群如高龄或存在基础疾病患者 [3](肺炎支原体和肺炎链球菌仍是第一位和第二位致病原)
2、我国CA-MRSA肺炎仅仅见于儿童及青少年的少量病例报道 [3]

初始治疗后72h内进行病情评价:
1、大多数CAP患者在初始治疗后72小时临床症状改善,但影像学改善滞后于临床症状;
2、应在初始治疗后72小时对病情进行评价,只要临床表现无恶化,可继续观察,不必急于更换抗感染药物(I A)。
CAP初始经验治疗成功的关键:
● 正确诊断是社区获得性肺炎治疗中贯穿始终的问题,且需不断修正
● 合理安排病原学检查,及时启动经验性抗感染治疗
● 抗生素治疗方案的选择应基于准确的评估病原体及其耐药性
● 初始治疗后72小时应对病情进行及时的评价
参考文献
[1] 刘又宁等. 中华结核和呼吸杂志, 2006;29(1):3-8
[2] Bao Z, Yuan X, Wang L, et al. Exp Biol Med (Maywood), 2012, 237(11) 1256-1261.
[3] 中华医学会呼吸病学分会.中华结核和呼吸杂志.2016;39(4):253-279.
作者介绍

孟爱宏,河北医科大学第二医院,呼吸内三科主任,医学博士、主任医师、博士生导师。中华医学会呼吸病学分会青年委员、中国医师协会对外交流委员会委员、中国医药教育协会呼吸病康复委员会常务理事/委员。

周广伟,医学硕士,主治医师。2003年就读于河北医科大学中西医结合专业,2008年获医学学士学位。2010年就读于河北医科大学第二医院呼吸内科学专业,2013年获呼吸内科学硕士学位。